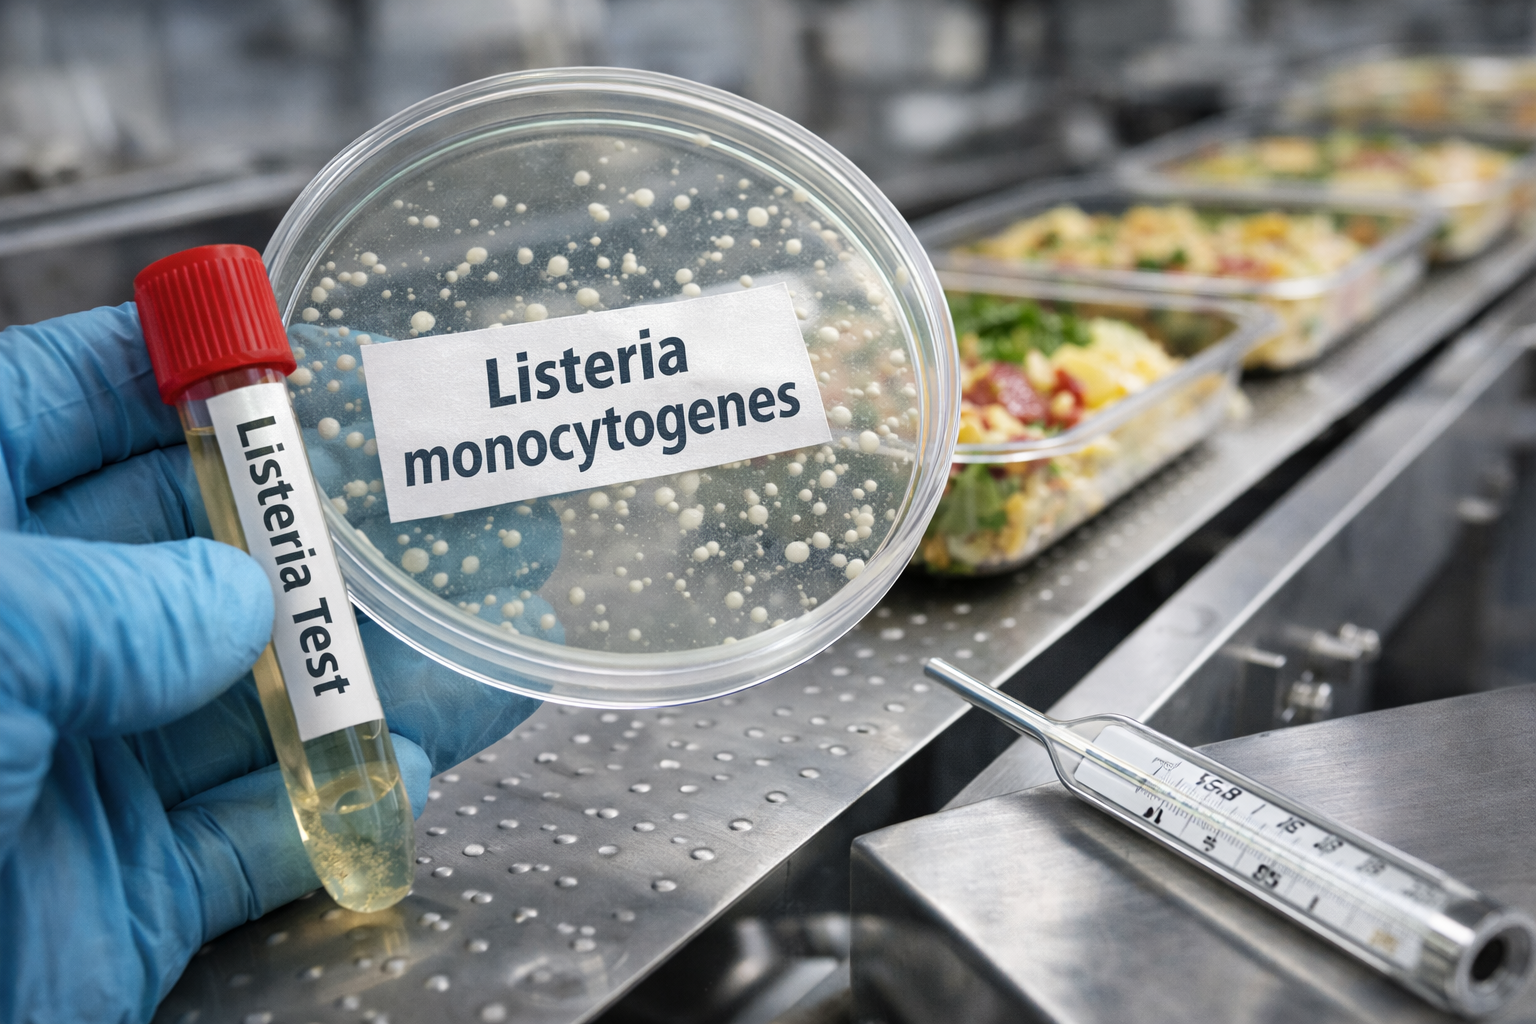

NVWA-boete of een Voornemen tot boeteoplegging ontvangen? Wat u direct moet doen en welke fouten u moet vermijden
Een NVWA-boete komt zelden gelegen. Vaak is er al druk op de operatie en ontstaat direct onrust binnen de organisatie. De reflex is begrijpelijk: snel reageren, uitleg geven en het probleem oplossen. Juist daar gaat het vaak mis. Bij handhaving door de NVWA is de eerste reactie juridisch vaak bepalend. Wat u in deze fase zegt of vastlegt, vormt de basis van het dossier en werkt door tot en met bezwaar en eventueel beroep.